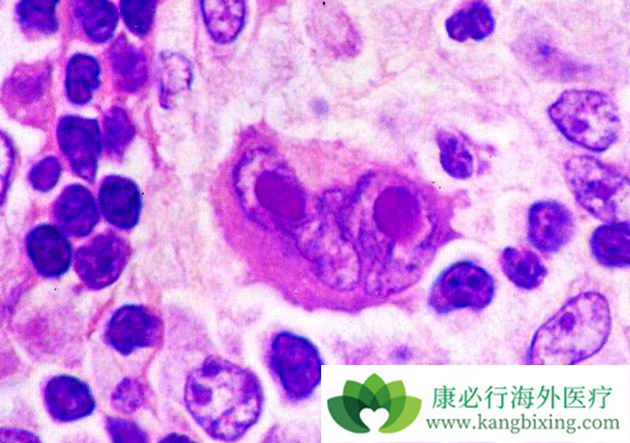

差不多在一年前,美国食品和药品管理局批准罗氏的利妥昔单抗(美罗华)联合人类透明质酸酶,治疗成人患者的滤泡淋巴瘤,弥漫性大 B 细胞淋巴瘤和慢性淋巴细胞性白血病。这项批准使患者能够皮下注射利妥昔单抗,与给药时间需数小时的静脉内输注相比可减少缩至 5 到 7 分钟。这项批准是基于多个随机临床试验的结果。
(a)1400 mg/23400 单位 Rituxan Hycela 的美罗华浓度(Ctrough)水平不低于静脉注射利妥昔单抗 375 mg/m2。(b)1600 mg/26800 单位 Rituxan Hycela 的 Ctrough 水平不低于静脉注射利妥昔单抗 500 mg/m2。(c)两种产品的疗效和安全性相当。药物处方信息中提供了试验结果。 FL 患者中观察到的最常见的不良事件(≥ 20%)包括便秘,咳嗽和疲劳。在 DLBCL 患者中观察到的最常见的不良事件(≥ 20%)包括脱发和贫血。
在CLL患者中观察到的最常见的不良事件(≥ 20%)为血小板减少症,发热,呕吐和注射部位红斑。三类患者都有报告常见不良事件如感染,中性粒细胞减少症,恶心。对于 FL 和 DLBCL,推荐的剂量为 1400 mg 利妥昔单抗(美罗华)和 23400 单位人透明质酸酶。用于 CLL 的推荐剂量为 1600 mg 利妥昔单抗和 26800 单位人透明质酸酶。患者通过静脉输注至少一次全剂量的利妥昔单抗产品后,才能启动 Rituxan Hycela 治疗。
详情请访问 肿瘤 http://www.kangbixing.com/

添加康必行顾问,想问就问












